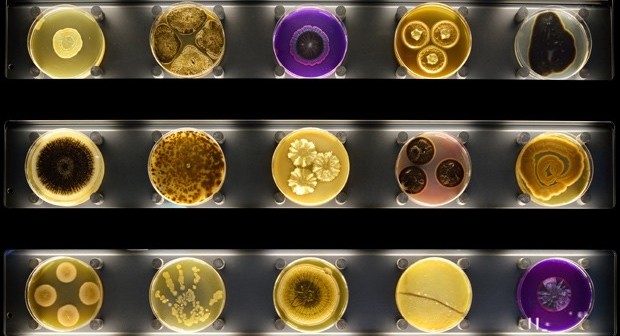
Imagem mostra placas de Petri com cultura de micróbios exibidas no museu Micropia, em Amsterdã (Foto: AFP Photo/Micropia/Maarten Van Der Wal)

Visitantes passam por ‘scanner’ que determina quantos micróbios vivem em seu corpo (Foto: AFP Photo/Micropia/Maarten Van Der Wal)
Inaugurado em Amsterdã primeiro ‘zoológico de micróbios’ do mundo
No local, visitantes podem ver um modelo em escala gigante do vírus ebola.
‘Beijômetro’ mostra quantos micróbios são trocados durante um beijo.
O primeiro “zoo interativo de micróbios” do mundo abriu as portas em Amsterdã no dia 30 de setembro de 2014, lançando nova luz sobre as minúsculas criaturas que compõem dois terços de toda matéria viva e são vitais para o futuro do nosso planeta.
Orçado em 10 milhões de euros (US$ 13 milhões), o Museu Micropia fica perto do zoológico real Artis, em Amsterdã, cujo diretor teve, há 12 anos, a ideia de expor um arranjo de micróbios vivos em um “microzoo”.
“Tradicionalmente, os zoológicos tendiam a mostrar apenas uma pequena parte da natureza, especificamente os animais maiores”, declarou Haig Balian à AFP.
“Hoje, nós queremos exibir a micronatureza”, disse Balian, que acredita que a importância dos micróbios nos nossos dias atuais tem sido subestimada desde que o cientista holandês Antonie van Leeuwenhoek viu as criaturas microscópicas no século XVII.
Frequentemente, os micróbios são associados a doenças, provocadas por vírus, bactérias, fungos e algas, mas eles também são essenciais para nossa sobrevivência e desempenharão um papel cada vez mais importante no futuro da humanidade e do planeta – acrescentou Balian.
“Os micróbios estão em toda parte. Portanto, precisamos de microbiologistas que sejam capazes de trabalhar em qualquer setor: nos hospitais, na produção de alimentos, nas indústrias petrolífera e farmacêutica, por exemplo”, afirmou.
Eles já são usados na produção de biocombustíveis, no desenvolvimento de novos tipos de antibióticos e no melhoramento da produtividade agrícola.
Experiências têm demonstrado seu potencial futuro em campos diversos, da geração de energia ao reforço de fundações de prédios, passando pela cura do câncer.
“Se deixarmos a ciência da microbiologia no escuro, relegada a alguns poucos especialistas, o interesse por ela nunca vai se desenvolver”, alegou Balian.
“Queremos mostrar aos visitantes como tudo na natureza está interconectado e como os micróbios, fundamentalmente, são parte dessa conexão”, acrescentou.
Cada humano adulto carrega no corpo cerca de 1,5 quilo de micróbios, e nós morreríamos sem eles.
Micróbios nos olhos e no beijo
Grande parte do museu – que alega ser o primeiro do mundo – se parece com um laboratório, com fileiras de microscópios conectados a enormes telões.
Os visitantes podem observar por uma janela um laboratório em tamanho real, onde diferentes tipos de micróbios se reproduzem em placas de Petri e tubos de ensaio.
Entrando em um elevador, é possível ver a imagem superaproximada de uma câmera no olho de alguém, revelando as minúsculas criaturas que vivem em nossos cílios. A câmera, em seguida, aproxima-se de uma bactéria no cílio e, finalmente, de um vírus dentro da bactéria.
Os visitantes podem ver a reprodução microbiana por um microscópio tridimensional, especialmente desenvolvido e construído para o Micropia, ou observar um modelo em escala gigante do vírus ebola, que está devastando o oeste da África.
Um “scanner” microbiano contará instantaneamente quantos micróbios vivem no corpo do visitante e onde.
Os visitantes mais corajosos poderão testar o “Beijômetro” (“Kiss-o-Meter”, em inglês) e saber quantos micróbios são trocados quando um casal se beija.
“Você sabia, por exemplo, que existem 700 espécies de micróbios vivendo na sua boca? Ou 80 tipos de fungos em seu calcanhar?”, perguntou Balian, com um sorriso nos lábios. “Uma visita ao Micropia mudará para sempre a forma como você vê o mundo”, concluiu.
(Fonte: http://g1.globo.com/ciencia-e-saude/noticia/2014/10 – CIÊNCIA E SAÚDE – Da France Presse – 01/10/2014)